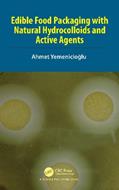

Edible Food Packaging with Natural Hydrocolloids and Active Agents
The aim of this book is to show the potential of natural hydrocolloids and active agents to develop sustainable edible packaging materials for food preservation. For this, the current and future sources of natural hydrocolloids have been reviewed along with their extraction methods, impact on health and ability to form different packaging such as film, casing, coating, mat, pad, etc. Similarly, natural active compounds were evaluated carefully considering their sources, extraction methods, regulatory status, and compatibility with edible packaging. The book emphasizes the recent developments in methods, strategies and technologies employed to enhance the performance of antimicrobial, antioxidant and bioactive packaging. The basic testing methods used to evaluate antimicrobial and antioxidant activity of edible packaging in model media and food were discussed, and carefully selected example active edible packaging applications for different food categories were provided with critical details such as the thin balance between effectiveness of packaging and sensory properties of food. As such, it helps in understanding necessary parameters in designing an effective active edible packaging that is applicable to the target food category. Moreover, readers are primed for the first time on how to develop a fully natural antimicrobial, antioxidant or bioactive edible food packaging. This book is different from most of the similar books' avail as it provides neither methodologies about classical active packaging based on chemicals and fossil polymeric films nor is it a thorough collection of different food packaging applications. It is also not a book that concentrates on physicochemical characterization methods and engineering aspects of packaging. Instead, this is a book that provides systematic knowledge about key methods of evaluating natural resources, agro-industrial wastes and by-products for development of edible packaging, and concentrates on concepts, strategies, technologies, and applications of active edible packaging based solely on natural components. It is designed to share both positive and negative experiences in an emerging field that is expected to play a central role in improving food safety and quality, human health and environmentally friendly practices.
-
Autore:
-
Editore:
-
Anno:2024
-
Rilegatura:Paperback / softback
-
Pagine:334 p.
Le schede prodotto sono aggiornate in conformità al Regolamento UE 988/2023. Laddove ci fossero taluni dati non disponibili per ragioni indipendenti da Feltrinelli, vi informiamo che stiamo compiendo ogni ragionevole sforzo per inserirli. Vi invitiamo a controllare periodicamente il sito www.lafeltrinelli.it per eventuali novità e aggiornamenti.
Per le vendite di prodotti da terze parti, ciascun venditore si assume la piena e diretta responsabilità per la commercializzazione del prodotto e per la sua conformità al Regolamento UE 988/2023, nonché alle normative nazionali ed europee vigenti.
Per informazioni sulla sicurezza dei prodotti, contattare productsafety@feltrinelli.it